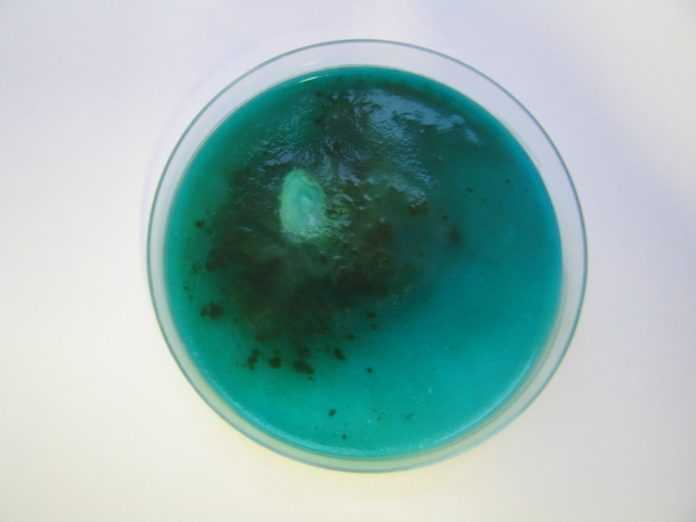
image

Содержание
Что показывает метод бактериального посева урины?
В условиях лабораторных исследований мочу помещают в специальную среду, благоприятную для развития и роста микроорганизмов. Причем для каждого из микроорганизмов необходимо своя среда обитания с правильно выбранным кислотным и водным балансом.
Если бактерии не распространяются по поверхности мочи, тогда тест считается отрицательным.
При повышенном размножении микроорганизмов специалисты делают вывод о положительных результатах. В таком случае пациенту нужно всерьез подумать о своем здоровье и не затягивать с проведением лечения.
Для того чтобы с точностью определить вид бактерий, поселившихся в организме человека, они проводят ряд специальных исследований. Если инфекция была обнаружена, на ней испытывают действие некоторых антибиотиков.
Посев мочи берут для того чтобы выявить количество патогенных микроорганизмов и установить возможные лекарственные препараты, которыми можно от них избавиться.
При подобном исследовании специалисты лаборатории ориентируются на нормативные показатели, установленные для медицинских стандартов.
Этот анализ выявляет и идентифицирует микроорганизмы, содержащиеся в урине. По результатам определяют их концентрацию, что позволяет установить уровень, на котором находится развитие аномальных изменений в организме индивида.
Бесспорное преимущество анализа мочи на
заключается в его высокой информативности и правильности результатов. Итоги лабораторных исследований дают уникальную информацию, которую невозможно получить с помощью других методов. К некоторым неудобствам следует отнести длительный срок проведения и увеличенные требования к чистоте обследуемого материала. Очень часто бак посев проводится для установления диагноза на следующие болезни:
- микоплазмоз – поражается мочеполовая система;
- уреаплазмоз – инфекция атакует половые органы;
- трихомониаз – самая распространенная инфекция мочеполовой системы в мире;
- кандидоз – развивается на фоне сниженного иммунитета.
- Назначение. Бактериальный посев используется для диагностики урологических инфекционных заболеваний.
- Методика забора. Необходима утренняя, первая порция мочи. Порция мочи должна быть средней. То есть, сначала пациент мочится в унитаз, затем – в стерильную емкость и снова в унитаз.
- Подготовка. Обязателен предварительный туалет половых органов. В особенности это важно, если пациент – женщина. Следует придерживаться тех же правил, что и при сдаче общего анализа мочи.
О чем расскажет анализ из уретры у мужчин
При каждом посещении гинеколога, врач берет мазок на флору. Для исследования материал берется специальным шпателем, далее наносится на стекло и окрашивается краской по методу Грамма. Это позволяет обнаружить возможные бактерии.
Благодаря данному методу можно получить сведения о количестве эритроцитов, лейкоцитов, возбудителей половых заболеваний (гарднереллы, трихомонады) и определить состав микрофлоры. Наличие лейкоцитов выше нормы указывает на воспалительный процесс, а эритроцитов – о примеси крови в выделениях.
Это позволяет определить не только возбудителя, но и количество патогенных микроорганизмов в мазке. Разница между двумя гинекологическими исследованиями в их проведении. Бактериальный посев является более информативным и при наличии патогенных микроорганизмов позволяет определить их чувствительность к антибиотикам.
Чтобы получить материал для исследования в необходимом объеме, в канал уретры мужчины вводят зонд на глубину около 3 см. При проведении данной процедуры обязательно используется одноразовый стерильный инструмент. После введения на достаточную глубину, зонд прокручивают, чтобы собрать выделения, затем извлекают и оставляют в пробирке для отправки в лабораторию. Пробирка обязательно должна иметь 100% стерильность.
На саму процедуру затрачивается всего несколько минут. Результат доктор может озвучить в течение одной недели, но, обычно на это уходит от двух до трех дней.
В большинстве случаев во время данной манипуляции возможен определенный дискомфорт. Хотя некоторые пациенты могут ощущать болевые симптомы и после процедуры в течение нескольких часов, после чего они сами по себе проходят, без дополнительного вмешательства. Но, если боль не проходит, а только усиливается, и появились гнойные выделения после соскоба – об этом безотлагательно следует поведать врачу.
Биоматериал берется из участка, где соединяется шейка матка и влагалище. Это цервикальный канал. Вместе с этим забор отделяемого делают из уретры и влагалища. Определение колониеобразующей единицы (КОЭ) помогает установить количество болезнетворных микроорганизмов в единице объема.
Подсчет колониеобразующих единиц может выполняться несколькими способами:
- Метод серийных разведений. Благодаря этому методу можно определить чувствительность бактерий к антибиотикам. 1 мл биоматериала разбавляется с посевом в пронумерованных пробирка с питательной средой. Пробирка, в которой рост колоний приостанавливается, считают максимальной границей концентрации бактерий в пробе.
- Подсчет колоний под микроскопом. Это ориентировочный метод, при котором подсчитывают колонии под микроскопом. Далее результаты интерпретируют в соответствии с таблицей.
- Секторный метод. Применяется для исследования степени бактериурии мочи.
- При исследовании устойчивости к антибиотикам применяют 2 метода: метод стандартных дисков и диффузный метод. После выращивания микроорганизмов в благоприятной среде в емкость опускают диски, которые пропитаны концентратом антибиотиков. Второй метод предполагает применение бумажных полосок с нанесением на них препарата.
Результаты бакпосева можно узнать по истечении 5 дней. В специальный бланк записывают патогенные микроорганизмы и их количество, заселяющие цервикальный канал.
Для получения достоверного результата следует правильно подготовиться к сдаче мазка:
- Во избежание присутствия других микроорганизмов в мазке, необходимо обеспечить стерильность взятого материала.
- Также следует отказаться от половых контактов за сутки до исследования.
- Нельзя проводить спринцевания, вставлять свечи и т.д.
- Не выполняется процедура в период менструации. Сдавать мазок можно только через 2 дня после их окончания.
- Если проводилась кольпоскопия, то бакпосев назначается через два дня.
- Не рекомендуется проводить посев, если женщина принимала антибактериальные препараты. Медикаментозное лечение может исказить результаты исследования и получить достоверную информацию о состоянии половых органов не получится. Таких же правил должен придерживаться мужчина, перед тем как сдать анализы.
- Перед забором мазка для исследования не следует проводить гигиену половых органов, использовать различные крема, гели для интимной гигиены и т.д.
Какие анализы назначает уролог
Для достоверности результата исследования следует правильно подготовиться к нему:
- Накануне сдачи анализа не пить много жидкости, так как это нарушит правильность результата, вследствие снижения числа бактерий в биологической жидкости.
- Отказаться от острой, соленой и жирной пищи, копченостей, пряных специй.
- Не употреблять алкогольсодержащие и газированные напитки.
- Не принимать витамины, мочегонные средства.
- Ограничить физическую нагрузку, не посещать сауну и баню.
- Приобрести в аптеке специальный контейнер для сдачи анализа мочи на посев.
- Для верного результата анализа следует исключить воздействие на флору лекарственных средств. При приеме пациентом антибиотиков посев делают только через семь дней после завершения курса лечения, а в идеальном случае через две.
Каких-либо медицинских знаний здесь не требуется, но учесть основные моменты необходимо, а именно:
- перед забором мочи прием антибиотиков прекращается;
- исключается употребление в пищу острых и соленых продуктов, а также сильно красящих фруктов и овощей, включая морковь, ягоды, свеклу и другие;
- прием всевозможных мочегонных препаратов недопустим;
- анализ сдается только после прекращения менструации;
- отбирается средняя порция биоматериала.
Собирать анализ мочи на посев, как и любой другой, необходимо утром, так как именно к этому времени мочевой пузырь соберет всю жидкость, а вместе с ней и имеющиеся бактерии. Забор мочи осуществляется сразу после пробуждения при первом мочеиспускании.
Забор мочи можно делать и в течение дня, по истечении двух часов после последнего мочеиспускания. Также нет никакого смысла сдавать анализ, если в этот период принимались антибиотики и витамин С, так как результат покажет недостоверные данные или бактерии вовсе не обнаружатся. Не следует на данный момент и пить слишком много воды.
По завершению процедуры жидкость плотно закрывается крышкой и доставляются в лабораторию. Сделать это нужно не позднее двух часов после окончания сдачи анализа. Важно собирать именно среднюю струю мочи, так как при этом исследования позволят определить наличие инфекции именно в мочевом пузыре, а не в уретре.
Внутренняя поверхность контейнера и крышка должны быть защищены от попадания посторонних предметов, а также прикосновений. Уже на большом сроке беременности, женщинам может быть сложно, сдавать данный анализ, поэтому им могут помочь сделать это при помощи катетера. Для этого необходимо обратиться в процедурный кабинет, который оснащен специальным креслом и оборудованием.
Часто мазок у мужчин из уретры берут с профилактической целью для уточнения общей картины состояния мочеполовой системы. Его в обязательном порядке назначают при планировании беременности или если у пары существует проблема с зачатием.
Сигналом к назначению бактериологического анализа могут служить следующие признаки:
- В исследуемой области появились сильный зуд или жжение;
- Половые органы покраснели или покрылись сыпью;
- Во время полового акта или же при мочеиспускании присутствуют любая боль и дискомфорт;
- В области канала мочеиспускания появились необычные выделения.
В каждом конкретном случае лечение должно быть индивидуальным. Это зависит не только от вида заболевания, но и от особенностей каждого отдельного организма. Обычно доктора назначают антибиотики, противовирусные и иммуномодулирующие препараты, а также местную терапию. Лечение должно быть комплексным и с точным выполнением всех предписаний лечащего врача.
Какие заболевания поможет определить анализ
Каким бы опытным не был врач, он не определит со 100% точностью причины проявления признаков воспалительного процесса или патологии. Он может их только предположить, но, окончательный диагноз поставит лишь после ознакомления с результатами полного лабораторного исследования.
При их выявлении уролог может назначить дополнительное исследование на определение количества и типа патогенных микроорганизмов.
Как собрать анализ мочи?
От правильного сбора биоматериала зависят данные результата бак посева, поэтому собирают его, выполняя следующие требования:
- Для анализа подходит утренняя порция урины, взятая сразу после сна.
- В течение двух часов после их сбора пробы должны быть доставлены в лабораторию.
- Предварительно следует произвести тщательный туалет половых органов. Женщинам лучше влагалище закрыть ватным тампоном.
- В контейнер берется средняя часть мочи. Начало и окончание мочеиспускания совершать в унитаз. Объем биоматериала должен быть примерно 10 мл.
- В холодное время года необходимо следить, чтобы биологическая жидкость не замерзла во время транспортировки.
Как долго делается анализ?
Точный срок готовности результатов может дать конкретная лаборатория, где производится обработка итогов исследования. Практика показывает, что анализ мочи на посев в среднем длится около десяти дней. Собранная урина помещается в специальную среду, в которой происходит размножение и рост бактерий.
Результат считается отрицательным, если количество микроорганизмов не увеличивается и положительным – в противном случае. Кроме их роста, обращают внимание и на концентрацию бактерий, при которой инфекция начинает быстро прогрессировать. При положительном итоге идентифицируется возбудитель болезни и выбирается результативное лекарственное средство для борьбы с инфекцией. В то же время делается анализ мочи на посев чувствительности к антибиотикам. Это очень важный момент для успешного прохождения курса лечения.
Правильная подготовка крайне важна
Для получения точного результата мужчине, который готовится сдать материал на бакпосев спермы, следует строго выполнять следующие рекомендации:
- за 5 — 6 дней до сдачи начать воздержание от сексуальной активности и мастурбации;
- за 7 дней до анализа отказаться от алкоголя и курения;
- за 4 — 5 дней исключить из рациона питания кушанья острые и соленые;
- сдавать анализ допускается только через 2 недели после завершения курса приема антибиотиков;
- время сбора семенной жидкости для образца – раннее утро до завтрака;
- сперму на исследование следует доставлять в лабораторию в стерильном контейнере, который открывается непосредственно перед сбором образца;
- до сбора эякулята необходимо совершить мочеиспускание, тщательно вымыть руки и половые органы, затем протереть все антисептиком;
- собирать сперму на анализ следует посредством мастурбации, следя, чтобы стерильной емкости не касались ни руки, ни половой член.
Это важно! Доверять проведение бакпосева спермы следует только надежной лаборатории. В случаях, когда материал собирается в домашних условиях, его необходимо доставить в лабораторию в течение 30 минут, не тряся контейнер и не позволяя ему оказаться под прямыми солнечными лучами.
Крайне важно, чтобы результаты бакпосева спермы были получены своевременно, причем сомнительные данные лучше всего перепроверить еще раз, так как неполучение качественно диагностики и последующего своевременного лечения грозит значительным распространением инфекционных поражений и потерей мужской фертильности.
Проведение анализа
Собственно анализ проводится следующим образом:
- Полученный для исследования образец спермы размещается в емкость со специальной питательной средой и условиями для быстрого размножения микроорганизмов.
- Несколько дней образец выдерживается при определенной температуре, благодаря чему выросшие микроорганизмы объединяются в заметные под микроскопом колонии.
- Специалист рассматривает анализируемую семенную жидкость, определяет наличие колоний бактерий, их классификацию, количество, скорость размножения. Сразу же определяется чувствительность выявленных микроорганизмов к разным антибиотикам.
Это важно! Исследование и расшифровка бакпосева спермы длится 5-8 дней, после чего на основании полученных данных лечащий врач разрабатывает соответствующую программу лечения.
Расшифровка
Расшифровка анализа представляет собой:
- качественную оценку образца (подтверждение наличия патогенов);
- количественную оценку (концентрацию микроорганизмов).
С точки зрения количественной оценки специалисты выделяют 4 степени роста патогенных микроорганизмов:
- 1 степень — скудный рост патогенов, возможный только в жидкой среде;
- 2 степень — рост бактерий и вирусов на плотной среде (каждый вид может быть представлен не более чем 10-ю колониями);
- 3 степень – на твердой среде появляется до 100 колоний;
- 4 степень – 100 и более колоний.
Первые две степени не считаются патологией и вероятнее всего означают, что исследуемый образец был неправильно взят или доставлен в лабораторию. При выявлении колоний 3-4 степени подтверждается наличие заболевания.
Это важно! Точная количественная оценка крайне важна, так как позволяет выявить конкретную степень роста патогенных микроорганизмов (а значит и определить правильное лечение), а также осуществить контроль над тем, правильно ли протекает терапия.
Автор Олег Добролюбов
Кандидат медицинских наук
Какой бы анализ не пришлось сдавать, для получения наиболее точного результата доктора предоставляют определенные рекомендации. Перед сдачей мазка на флору они советуют:
- За неделю до проведения процедуры следует перестать принимать лекарственные препараты, которые не согласованы с лечащим врачом;
- В течение двух суток необходимо полное воздержание от интимной близости;
- Перед соскобом, чтобы не исказить результат, примерно за два часа не стоит мочиться;
- Гигиенические процедуры следует проводить накануне вечером, а не перед посещением доктора.
Работа над результатами
По итогам анализа выявляют информацию о колониеобразующих единицах, которая указывает на количество в 1 мл мочи жизнеспособных микроорганизмов. Совокупность клеток образует колонию. В распечатке результатов анализа будут перечислены все виды микроорганизмов: бактерии, грибы, простейшие с указанием их количества в миллилитре биологической жидкости (КОЕ/мл). Кроме этого, будет представлен перечень лекарств, чувствительных к каждому из перечисленных бактерий.
Расшифровка анализа посева мочи показывает, что если значение КОЕ/мл:
- Меньше 1000, то это считается нормой и пациенту не требуется никакого лечения.
- При показаниях от 1000 до 100 000 необходимо бак посев повторить. Скорее всего, были нарушены правила подготовки или сбора анализа урины.
- При показателях больших 100 000 в моче содержатся болезнетворные микроорганизмы, следовательно, необходим курс лечения, который подберет лечащий врач.
Специалистам требуется до двух недель, чтобы провести все необходимые мероприятия и огласить свой вердикт. Очень важно соблюдать правила гигиены, перед тем как сдавать посев мочи.
Объясняется этот тем, что в организме человека содержатся бактерии, которые не нарушают микрофлору уретры, однако если их количество будет превышено, то начнется процесс развития инфекции и все вытекающие из этого последствия. Основная оценка бак посева мочи происходит в колониеобразующих единицах.
Результат будет считаться отрицательным, если при помещении биологического материала в питательную среду живая микробная клетка (КОЕ) не будет развиваться.
При обратной реакции необходимо провести ряд дополнительных исследований и сравнений, чтобы определить точное количество выявленных микроорганизмов. Осуществляется их точный анализ, определяет тип при помощи просмотра под микроскопом. Также важно правильно определить чувствительность микрофлоры к антибиотикам.
При значении 100000 КОЕ/мл можно говорить о наличии инфекции. Сомнительный результат, требующий дополнительных мероприятий или даже повторного исследования, равняется 1000 – 10000 КОЕ/мл.
Расшифровка полученных анализов должна проводиться только квалифицированным специалистом, который сможет назначить правильное и грамотное лечение на основе выявленных данных, если все правила были соблюдены.
Как проводится анализ мочи на посев?
Бактериурия – это присутствие в моче бактерий. У этого явления две разновидности: истинная и ложная. Истинная – это, когда микроорганизмы размножаются в мочевыводящих путях. Попадание бактерий в урину через почки из других органов происходит при ложной бактериурии. Как одна, так и другая разновидности могут протекать без всяких симптомов. Это еще раз подтверждает значимость проведения посева урины для обнаружения заболевания на ранней стадии.
Анализ на посев может занять около 10 дней. Биоматериал в лаборатории размещают в питательную среду, и в течение суток она находится в инкубаторе. Выросшие бактерии еще раз высевают, но уже в чашке Петри и снова ставят на сутки в инкубатор. Далее, получившиеся колонии бактерий продолжают выращивать еще некоторое время.
Какими должны быть дальнейшие действия
Когда анализ получен и доктор озвучил неутешительный результат, многие мужчины впадают в панику. Но, этого допускать не стоит ни в коем случае, ведь любое из заболеваний мочеполовой сферы, которое определяется мазком, можно вылечить. Ни в коем случае не стоит заниматься самолечением по принципу «а соседу помогло».
Иногда он может направить на дополнительные анализы, но, если такая необходимость отсутствует, сразу же назначается должная схема лечения.
Как сдавать анализ мочи на бак посев во время беременности?
Расшифровать анализ не представляет особого труда, если знать единицу измерения количества микроорганизмов и пределы нормы, в которые должны укладываться показатели мочи.
В результатах будут указаны виды микроорганизмов, присутствующих в моче, а также наличие грибов, если они также имеются в урине. Дополнительно будут обозначены препараты, способные справиться с этими возбудителями.
(Картинка кликабельна, нажмите для увеличения)
В полученном результате пациент найдет аббревиатуру КОE. Она обозначает колониеобразующую единицу и берется для расчета наличия бактерий в организме.
Если величина колониеобразующей единицы менее одной тысячи, тогда лечение не требуется, а число микроорганизмов, обитающих в моче, считается нормальным показателем.
Если колониеобразующая единица достигает более одного миллиона частиц, такие сведения свидетельствуют об обширном воспалительном процессе или инфекционном поражении мочевого пузыря.
Если бактерии находятся в незначительном превышении нормы, тогда речь идет о воспалительном процессе или очаге инфекции, которые недавно зародились в мочевыводящих путях или мочевом пузыре.
Помимо определения видов возбудителей необходимо понять их реакцию и чувствительность на воздействие различных антимикробных средств. Поэтому специалисты осуществляют антибактограмму.
Антибактограмма позволяет выявить препарат, который способен уничтожить возбудителей и поможет составить правильную схему лечения для врача.
Микроорганизмы обозначают латинскими терминами, а напротив них ставят отметки так же латинской буквой. Если напротив возбудителя стоит буква «S», тогда следует считать, что возбудитель уязвим к данному препарату. Если специалист поставил букву «R», тогда это лекарственное средство не подойдет для проведения успешного лечения.
Анализ мочи на посев при беременности считается одним из самых важных. Его назначают сразу после постановки женщины на учет, а также в третьем триместре. Делается это в целях сохранения здоровья будущего малыша. Хроническую или бессимптомную форму инфекционной болезни мочеполовой системы будущая мама некоторое время может и не заметить, а результаты общего анализа мочи могут быть в норме. Только анализ посева мочи на флору может выявить скрытую форму заболевания.
Неправильный забор мочи нередко искажает результаты анализов. Поэтому необходимо соблюдать некоторые простые правила:
- заблаговременно приобрести в аптеке специальную пластиковую емкость для сбора мочи;
- за сутки исключить из рациона продукты, окрашивающие мочу;
- не принимать мочегонные и другие лекарственные средства, которые могут исказить итоги исследования;
- снизить физическую нагрузку, чтобы не увеличивать количество белковых веществ в моче;
- воздержаться от полового акта;
- тщательно вымыть наружные половые органы и насухо вытереть салфеткой;
- прикрыть отверстие влагалища стерильным ватным тампоном, чтобы в мочу не попали частички выделений;
- собрать утреннюю порцию биоматериала в подготовленный контейнер, взяв только ее среднюю порцию; для анализа достаточный объем составляет 10 мл;
- контейнер с содержащейся биологической жидкостью доставить в лабораторию в течение двух часов после сбора.
Бывает, что исследование на бак посев мочи, которую собрали обычным способом, не дает четкой картины. В этом случае делают пункцию в лобковой области и берут биологическую жидкость, исключая любые загрязнения. Получив направление на исследование, следует ознакомиться, как сдавать анализ мочи на посев, чтобы результаты не исказили истинной картины состояния здоровья мамы и будущего малыша.
В организме любого здорового человека содержатся различные болезнетворные микроорганизмы. При их небольшом количестве – человек здоров. Расшифровка результатов анализа осуществляется доктором. При этом он учитывает результаты других исследований, наличие токсикоза и общего состояния роженицы. Норма бак посева при беременности ничем не отличается от нормы здорового человека в обычном состоянии.
Анализ мочи на посев показывает, что только при значениях больше, чем 10 000 КОЕ/мл в организме беременной женщины обнаруживают патогенные микроорганизмы. В такой ситуации лечащий доктор назначает соответствующее лечение, чтобы мама и плод чувствовали себя нормально и были здоровы. После завершения курса терапии, который обычно длится три недели, назначают повторную сдачу анализа мочи на бактериологическое исследование.
Пиелонефрит у беременной женщины
Нередко у женщин в положении обнаруживают воспалительный процесс в почках, причинами которого могут быть:
- Уменьшение тонуса мочеточников. Под воздействием гормонов изменяется структура мочеточников, в результате снижается их тонус, что приводит к застойным явлениям мочи, для патогенных микроорганизмов образуются комфортные условия для размножения.
- Увеличение размера матки. Мочевыводящие пути сдавливаются все время растущей маткой и как результат моча застаивается.
- Гормональные сбои. Нарушения оттока урины происходит и из-за расширения яичниковых вен, которые сдавливают мочеточник.
Пиелонефрит может послужить причиной внутриутробной инфекции и привести к самопроизвольному выкидышу, а в третьем триместре к преждевременному родоразрешению. Выявить болезнь на ранних стадиях, и своевременно начать лечение – это значит спасти жизнь и здоровье будущего малыша.
Подводя итоги
Многие заболевания протекают в скрытой форме и практически без симптомов. Если вдруг было замечено что-либо необычное со стороны организма – не стоит откладывать визит в поликлинику. Признаки не пройдут сами собой, особенно если это серьезное заболевание.
Бак посев из уретры у мужчин является наиболее быстрым, а также довольно информативным исследованием. Своевременная сдача анализов вместе с лечением в большинстве случаев дают 100% результат скорейшего выздоровления и сводят к минимуму вероятность последствий. Но, при наличии инфекционных заболеваний, если мужчина ведет половую жизнь, его партнерше также необходимо обследоваться на присутствие подобных микроорганизмов. Иначе все лечение может свестись к нулю, так как они будут постоянно передаваться от одного к другому.
Пускать все дело на самотек не стоит. Само собой ни одно заболевание не проходит. Кроме того, помимо неприятного дискомфорта, патология микрофлоры может привести даже к бесплодию. При ее наличии сперма изменяет свое качество и в семенной жидкости появляются неподвижные сперматозоиды.
Любая инфекция может развиваться стремительно. Если ее вовремя не обнаружить и не избавиться от нее, заболевание может постепенно перейти в хроническую форму, с которой бороться будет практически невозможно. Ведь любой хронический процесс до конца не убивается, а периодически проявляется в виде новых обострений. А это порой приводит мужчин даже к импотенции.
В заключение
Один из самых результативных и наиболее достоверных анализов – это бактериологический посев мочи, который позволяет выявить различных возбудителей инфекционной природы мочеполовой системы и оценить их концентрацию.
Медицинские работники бак посев мочи назначают в профилактических целях, только что заболевшим пациентам и хроническим больным. Результаты бактериологического посева урины дают доктору возможность приобрести исключительную информацию, которую другими исследованиями не определить.